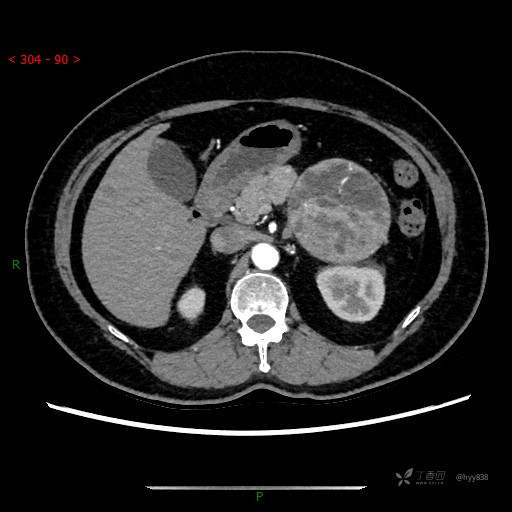
img
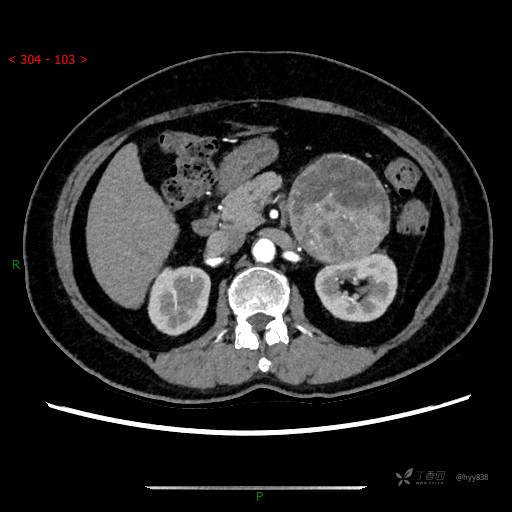
img

庆新年病例分享|腹膜后肿物,很多战友可能误诊,have a try---结果公布~
患者性别:男
患者年龄:59岁
简要病史:外院超声体检偶然发现肾脏肿物,门诊以肾脏肿瘤收入院
体格检查:(-)
辅助检查:CT
临床诊断:肾肿瘤
治疗经过:手术
讨论:病变性质?
中腹部CT平扫







增强动脉期





增强静脉期






患者性别:男
患者年龄:59岁
简要病史:外院超声体检偶然发现肾脏肿物,门诊以肾脏肿瘤收入院
体格检查:(-)
辅助检查:CT
临床诊断:肾肿瘤
治疗经过:手术
讨论:病变性质?
中腹部CT平扫







增强动脉期

增强静脉期






